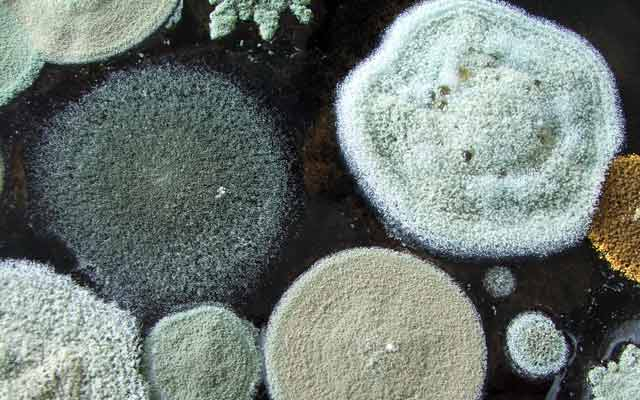
Az új házat is szereti a penész

Hírek
2014. Május 07. 05:00, szerda |
Belföld
Forrás: OrientPress Hírügynökség
Az új házat is szereti a penész
A lakóházak tervezési, kivitelezési vagy karbantartási hibáiból fakadóan penészgomba mind az új, mind a régi épületeknél közel azonos arányban fordulhat elő.
Magyar Donát, a Budai Allergiaközpont aerobiológusa szerint a penészspórákat gyakran az új építésű falak nedvessége élteti, de megbújhatnak a padlás gerendáiban, vályogház esetében pedig a feldolgozott szalmában is.
Miért fordul elő új építésű házaknál penészesedés?
Az épületek tervezésénél ma az energiatakarékosság a fő vezérelv, és csak ritkán vesszük figyelembe az egészségi szempontokat. Fontos, hogy az építést, - de az átalakítást, utólagos szigetelést is- megfelelően képzett szakember felügyelje. Az új építésű házaknál sok gondot okoz a falakban maradt építési nedvesség. A sürgető határidők miatt túl korán átadott épületnek még nincs ideje kiszáradni. Másik gyakori eset, hogy a tervezés, illetve kivitelezés során kispórolt vagy olcsóbb, de nem megfelelő építőanyagok révén káros folyamatok indulnak el az épületben. A nem megfelelő termékkel önkényesen helyettesített szigetelőanyagok kárt okoznak az épületben és a lakók egészségében egyaránt.
Megoldást jelent, ha a penészt rendszeresen eltávolítjuk?
A penészesedés kapcsán nyilván a külső falakon, sarkokban, esetleg fürdőszobában, a kád mellett megjelenő sötét foltra gondolunk, a helyzet azonban nem ennyire egyszerű. Többször találkoztunk már olyan esettel, amikor a lakásban a penésznek látható jele nem volt. Egy újépítésű társasház gyerekszobájában például a fal az átadás-beköltözés után, közel másfél évig tartotta a nedvességet. A babaágy fölötti fehér falon fehér színű Aspergillus penészgombafaj telepedett meg. A szülők sokáig észre sem vették a „magát jól álcázó” gombát. Mivel a gombatelep közvetlenül a kiságy felett volt, a spórák nagy mennyiségben szóródtak oda.
A nedvesség a beépített faanyagban is megmaradhat. Egy új építésű ház padlásán a gerendákat gomba lepte el. Innen a szennyeződés könnyen lejuthat a lakótérbe, mert a padlás csapóajtaja a nappali mennyezetének közepén nyílt, és még ráadásul rosszul is szigetelték. A válaszom tehát az, hogy nem elég pusztán eltávolítani a penészt, hanem az azt kiváltó okot kell megkeresni és megszüntetni.
Milyen problémák jelentkezhetnek a régi építésű házaknál?
Sajnos e téren sem kedvezőbbek a tapasztalataink, sok problémás esettel találkozunk. Egy többgyermekes család vályogházba költözött, melynek egészségügyi hatásával szerettek volna tisztában lenni. Az épületben váratlan helyen bukkantunk az allergénforrásra: a padláson a vályogba bedolgozott szalma töreken alakultak ki, egy gomba telepei. A gombát csak mikroszkópos vizsgálattal lehetett kimutatni, de a szabad szemmel láthatatlan spórái a födém áttöréseken keresztül akadálytalanul alápereghettek a lakásba. A penészgombák spórái akár az alig látható, fél milliméteres repedéseken is átjutnak, hiszen kis méretük (0,002-0,005 mm) alapján ez könnyen lehetséges. A gombaspórák pincékből is bejuthatnak a lakótérbe, ablakokon át vagy csövek mentén.
Egy másik esetnél, a családi ház pelletkazánját gyümölcsmagokkal fűtötték. A pincében raktározott magok bepenészedtek és a spórák a szennyesledobón át a meleg levegővel felszállva elárasztották a lakást. A különleges alapanyagnak és tárolási körülményeknek köszönhetően ritka, lakásokra nem jellemző gombafajok okoztak panaszt. Egy másik esetben az előző lakó a penészes falat egyszerűen egy papírtapétával leragasztotta- ez tartott is, amíg a lakást el nem adta. A porózus épületanyagok,szőnyegpadlók még kiszáradásuk után is tartják magukban a baktérium- és spóratömeget; ezek közelében a szennyezőanyag magas légköri koncentrációja mérhető.
Hogyan előzhetjük meg a bajt?
Használt lakás vásárlásakor jogosan tarthatunk attól, hogy az előző tulajdonos bizonyos előnytelen tényezőket nem hoz a lakásvásárlók tudomására. Sokszor azonban még ők sem tudnak az épület gyenge pontjairól - azokról, amelyek később allergiás megbetegedéseket kialakulásához vezethetnek a gyerekeknél. Amennyiben légúti allergiás beteg van a családban, a lakás, ház vásárlása előtt érdemes aerobiológiai vizsgálatot végeztetni, amellyel az (el)rejtett allergénforrások kimutathatók. Az allergéneket felderítő helyszíni vizsgálat gyakran olyan szennyező forrást mutat ki, melynek elhárítása nem jelent komoly gondot, az adásvételt nem vétózza meg- viszont elkerülhető általa, hogy ismeretlen eredetű légúti tünetekkel szembesüljenek az új lakók.
Új lakások esetében a legtöbbször csak a beköltözés után derül fény a problémákra. Az építészeti hiányosságok miatt felmerülő károk felmérésére biztosítás, kártérítés, vagy peres eljárás keretében igazságügyi szakértőket, elsősorban építészeket kérnek fel. A tapasztalataink szerint még kevesen veszik igénybe, de érdemes tudni, hogy az anyagi kár mellett az egészségben okozott kár bebizonyítására és visszatérítésére is van lehetőség- ezt a vizsgálatot igazságügyi allergológus szakértő orvos végzi.
Ezek érdekelhetnek még
2026. Február 08. 11:00, vasárnap | Belföld
Az ötös lottó nyerőszámai és nyereményei
A Szerencsejáték Zrt. tájékoztatása szerint a 6. héten megtartott ötös lottó és Joker számsorsoláson a következő számokat húzták ki:
2026. Február 08. 08:30, vasárnap | Belföld
Orbán Viktor: arról, hogy megyünk-e háborúba vagy kimaradunk, a 2026-ban megválasztott kormány fog dönteni
Arról, hogy megyünk-e háborúba vagy kimaradunk, a 2026-ban megválasztott kormány fog dönteni - mondta Orbán Viktor miniszterelnök a Digitális Polgári Körök szombati háborúellenes gyűlésén Szombathelyen.
2026. Február 08. 07:00, vasárnap | Belföld
Magyar Péter: véget vetünk az elszalasztott lehetőségek időszakának
Április 12-én egyszer és mindenkorra véget vetünk az elszalasztott lehetőségek korszakának, az Orbán-Gyurcsány-korszaknak, a hanyatlásnak, az önkénynek és a közjavak szétlopásának
2026. Február 07. 16:00, szombat | Belföld
Hegyi Zsolt: minden eddiginél nagyobb lépés történt a MÁV-flotta megújítása felé
Plusz 50 ezer vasúti ülőhely: mintegy 100 távolsági és elővárosi motorvonat, csaknem 90 új InterCity-kocsi

